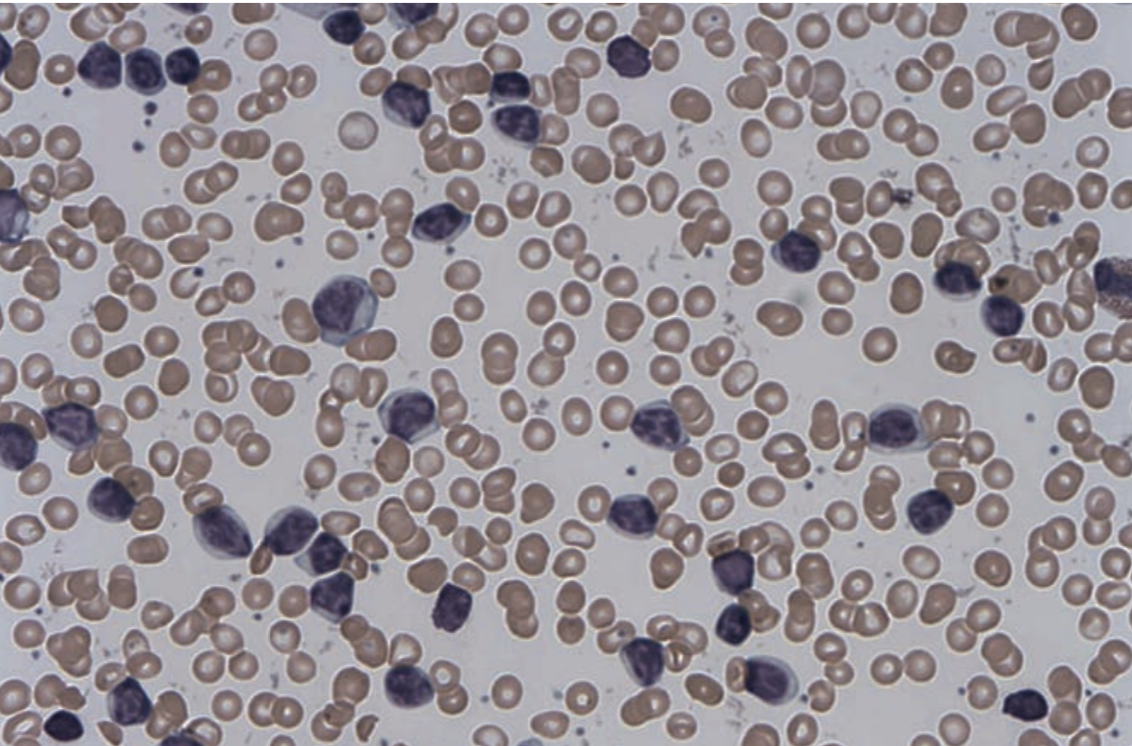

Hematologic Oncology
Latest News
Latest Videos

CME Content
More News

The FDA is set to review a supplemental new drug application for ibrutinib in combination with rituximab for the treatment of Waldenström’s macroglobulinemia.

Though steroids currently remain the standard frontline treatment for patients with immune thrombocytopenia, second-line treatment options for this patient population are rapidly expanding.

A study presented at the AACR Virtual Annual Meeting II indicated that Hispanics are diagnosed with blood cancers at a significantly younger age than non-Hispanic white individuals.

Principia Biopharma announced positive data on the durability of response from an ongoing phase 1/2 trial of the investigational treatment in patients with immune thrombocytopenia.

The MD Anderson expert discussed the phase 3 trial – designed to evaluate frontline eprenetapopt in combination with azacytidine (Vidaza) in patients with TP53-mutant positive myelodysplastic syndrome (MDS) – that recently completed full enrollment.

These study findings indicated that primary hemostasis and bleeding are dynamic and more interdependent than platelet counts and bleeding in extremely preterm neonates with thrombocytopenia.

The trial compared zanubrutinib, a potent and selective BTK inhibitor, versus ibrutinib, a first generation BTK inhibitor, in patients with Waldenström macroglobulinemia.

The study evaluated the use of axicabtagene ciloleucel (axi-cel) in patients with relapsed or refractory indolent non-Hodgkin lymphoma.

Nirav Niranjan Shah, MD, spoke about the use of autologous stem cell transplant in patients with relapsed, chemosensitive DLBCL during the era of CAR T-cell therapy.

The FDA granted fast track designation for CLR 131 in lymphoplasmacytic lymphoma/Waldenstrom’s macroglobulinemia in patients having received 2 prior treatment regimens or more.

An international working group of experts in myelodysplastic syndromes proposed the recognition of the SF3B1 variant as a distinct nosologic entity based on the presence of a non-inheritable genetic mutation that causes the disease.

Researchers suggested that treatment-free remission may be successfully obtained with an effector-suppressor score which is calculated using absolute natural killer cells, FoxP3+ regulatory T cells, and monocytic myeloid-derived suppressor cells.

The oncology hematologist spoke about the guidelines she and her colleagues outlined regarding treating patients with hematologic malignancies during the COVID-19 pandemic.

The FDA granted orphan drug designation to Ascentage Pharma’s HQP1351 for the treatment of chronic myeloid leukemia.

The FDA approved the use of daratumumab and hyaluronidase-fihj (Darzalex Faspro) in adult patients with newly diagnosed or relapsed/refractory multiple myeloma.

Given that thrombotic risk is significantly affected by race, researchers suggested that these findings may indicate that pulmonary vasculopathy may contribute to the unexplained differences in racial susceptibility to COVID-19 mortality.

Data from the phase III REACH2 study indicated that ruxolitinib therapy led to significant improvements in efficacy outcomes in patients with steroid-refractory acute graft-versus-host disease.

The International Lymphoma Radiation Oncology Group laid out a set of emergency recommendations for alternative radiation treatment schemes for treating patients with hematologic malignancies during the COVID-19 pandemic.

Mount Sinai Health System announced that they will be using the allogeneic stem cell therapy remestemcel-L in patients with COVID-19, and have already tested the therapy in 10 patients.

MBI-LCBI, with the addition of any bloodstream infections, was associated with significant morbidity and mortality in this patient population.


This study indicated that caregivers saw improved quality of life, reduced caregiving burden, lower anxiety and depression symptoms, and improved self-efficacy and coping skills having received psychosocial intervention.

The FDA granted a breakthrough therapy designation to abatacept for the prevention of moderate to severe acute graft-versus-host disease in hematopoietic stem cell transplants from unrelated donors.
The treatment landscape for chronic lymphocytic leukemia has dramatically changed in the past decade.

The agency approved the first and only FDA-approved erythroid maturation agent to treat anemia in adult patients with beta thalassemia who require regular red blood cell transfusions.














































